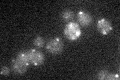
YLR191W

View description
Integral peroxisomal membrane required for the translocation of peroxisomal matrix proteins, interacts with the PTS1 signal recognition factor Pex5p and the PTS2 signal recognition factor Pex7p, forms a complex with Pex14p and Pex17p
Localization:
Intensity:
Fold change:
Significance:
-
C’ GFP library in SD

punctate23.58 -
N' NOP1pr-GFP in SD

punctate40.525 -
N' TEF2pr-mCherry in SD

punctate65.2844 -
N' NATIVEpr-GFP in SD

punctate26.9674 -
N' TEF2pr-VC and Cyto-VN in SD

punctate30.4315 -
C’ GFP library in SD+DTT

punctate23.751No -
C’ GFP library in SD+H2O2

punctate20.750.88No -
C’ GFP library in Starvation Media
punctate20.870.88No -
C’ GFP library on the background of Pup2-DaMP

N/A -
C’ GFP library on the background of CCT mutant

N/A0N/AYes
